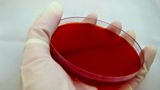

All Programmes A to Z - F
- Available Programmes
- All Programmes
-
![]()
A Funny Thing Happened on the Way to the Despatch Box
Marcus Brigstocke assesses the performances of our elected representatives.
��ѿ��ý Radio 4
-
![]()
-
![]()
Funny Turns
The best of Scotland's stand up comedians, presented by Fred MacAulay.
��ѿ��ý Radio Scotland
-
![]()
-
![]()
Funny Women Finals 2009
Stand Up Comedy from the Funny Women final filmed at The Comedy Store in London on Sept 21
-
![]()
-
![]()
The Furchester Hotel
Join Elmo, the Cookie Monster and their puppet family for mishaps and mayhem.
CBeebies
-
![]()
The Furchester Hotel
Join Elmo, Phoebe and the rest of their family for loads of fun and games!
CBeebies Radio
-
![]()
The Further Adventures of Sherlock Holmes
Series of stories continuing the exploits of Arthur Conan Doyle's great detective
��ѿ��ý Radio 4 Extra
-
![]()
Further Back in Time for Dinner
A family travel through time to discover how food has transformed the way we live.
��ѿ��ý Two
-
![]()
Further Education
Helping 16–19 year old vocational students with literacy, numeracy and ICT skills.
��ѿ��ý Two
-
![]()
A Further Five Numbers
Simon Singh investigates the history of the most special numbers in maths
��ѿ��ý Radio 4
-
![]()
Fusion Lunch & Learn: Gaming and Esports
Opportunities for the ��ѿ��ý within the gaming space and how it can appeal to audiences
��ѿ��ý Live Streams
-
![]()
Fusion Lunch & Learn: Strictly Tech 2019
Hosted by Jatin Aythora, Chief Architect, TS&A
��ѿ��ý Live Streams
-
![]()
Fusion Sounds Amazing 2023
See the latest innovations in AI and personalised audio.
��ѿ��ý Live Streams
-
![]()
-
![]()
-
![]()
-
![]()
-
![]()
-
![]()
-
![]()
Fusion: What on Earth is COP26?
AKA the most important conference for Planet Earth (arguably) ever.
��ѿ��ý Live Streams
-
![]()
-
![]()
Fusion/Lunch & Learn: Global Perspectives on Technology
How can we use it to help our audiences flourish? Emily Hawes, Senior M&A Planner
��ѿ��ý Live Streams
-
![]()
Fusion/Lunch & Learn: It's Bigger on the Inside: The ��ѿ��ý+ Journey
Gabriel Straub discusses the ��ѿ��ý+ app.
��ѿ��ý Live Streams
-
![]()
-
![]()
-
![]()
Future Art
James Fox steps into the future to ask how technology is transforming the art world.
��ѿ��ý Radio 4
-
![]()
The Future by Naomi Alderman
A new novel from the author of The Power set in a future we could be heading to very soon.
��ѿ��ý Radio 4
-
![]()
-
![]()
Future Earth
Carl Nasman explores today's most important developments in climate and sustainability.
��ѿ��ý News
-
![]()
Future Empire-fect
Andy Zaltzman and Anuvab Pal explore the future of the UK-India relationship.
��ѿ��ý Radio 4
-
![]()
Future Fashions with Sylvia Anderson
A look at future fashions with the voice of Lady Penelope.
��ѿ��ý Four
-
![]()
Future Festival
A night of live performances from the legendary ��ѿ��ý Maida Vale Studios.
��ѿ��ý Radio 1
-
![]()
Future Food
A 5 live special exploring where your food may come from in the future.
��ѿ��ý Radio 5 Live
-
![]()
Future ��ѿ��ý of the Living God by Louise Erdrich (Omnibus)
With the world in crisis, evolution goes into reverse. Louise Erdrich's novel.
��ѿ��ý Radio 4 Extra
-
![]()
The Future Is Halal
Navid Akhtar investigates the huge global rise of halal products and services.
��ѿ��ý Radio 4
-
![]()
The Future Is Not What It Used to Be
How will the workforce of the future be changed by advanced technologies?
��ѿ��ý Radio 4
-
![]()
-
![]()
-
![]()
Future Of Blast Furnaces Uncertain
UK Business Secretary refuses to say if British Steel's blast furnaces can keep running
��ѿ��ý News
-
![]()
-
![]()
-
![]()
-
![]()
-
![]()
-
![]()
The Future of Leadership
Margaret Heffernan argues existing models of leadership have outlived their usefulness.
��ѿ��ý Radio 4
-
![]()
The Future of Parliament Lecture
Speaker of the House of Commons John Bercow delivers a lecture: the Future of Parliament.
��ѿ��ý Parliament
-
![]()
-
![]()
The Future Of Sex
We explore the future of sex by taking a closer look at the technology behind sex robots.
��ѿ��ý Radio Wales
-
![]()
Future of Tech
What are some exciting technological developments gearing up to change our lives?
��ѿ��ý News
-
![]()
The Future of the Dollar
Ngaire Woods investigates the role of the dollar as the world's leading currency, and w...
��ѿ��ý World Service
-
![]()
The Future of the Past - Early Music Today
Nicholas Kenyon tells the story of the pioneers of the period instrument revival.
��ѿ��ý Radio 3
-
![]()
The Future of the Political Interview
David Dimbleby lectures on The Future of the Political Interview, from Friday 17 July.
��ѿ��ý Parliament
-
![]()
Future Perfect
Peter Day examines the main forces thought to provoke a change in the 21st Century
��ѿ��ý World Service
-
![]()
Future Planet
Future Planet looks at ways we can make our world a more sustainable place.
��ѿ��ý News
-
![]()
-
![]()
The Future Seekers
Exploring the long-running science experiments that might give us hope for the future
��ѿ��ý Radio 4
-
![]()
Future Sounds Collective from Radio 1
Songs you have to hear, selected by a community of artists, DJ’s and producers
��ѿ��ý Radio
-
![]()
Future Speak
Tom Armitage decodes digital literacy for the so-called 'second machine age'.
��ѿ��ý Radio 4
-
![]()
The Future State of Welfare with John Humphrys
John Humphrys talks to people with the most to lose if the welfare state is eroded.
��ѿ��ý Two
-
![]()
Future Tense - The Story of H.G. Wells
How did a sleepy corner of the country inspire some fantastic science fiction ideas?
��ѿ��ý One
-
![]()
Future Warfare
The future of warfare lies beyond battlefields to the uncharted reaches of outer space and even to the digital realm.
��ѿ��ý Persian TV
-
![]()
The Future Will Be Synthesised
Henry Ajder examines the implications of the synthetic media seeping into our lives.
��ѿ��ý Radio 4
-
![]()
The Future with Hannah Fry
Mathematician and author Professor Hannah Fry explores the science, technology, and people on the cusp of the most transformative breakthroughs of our age.
تلفزيون بي بي سي عربي
-
![]()
FutureProofing
Series examining the big ideas that are set to transform the way society functions
��ѿ��ý Radio 4
-
![]()
FutureProofing
Examining the big ideas that are set to transform the way society functions.
��ѿ��ý Radio 4
-
![]()
Futureshock! The Story of 2000AD
Phill Jupitus tells the story of the weekly British comic 2000AD, now 30 years old.
��ѿ��ý Radio 4
-
![]()
Fy Achau Cymraeg
Straeon am siaradwyr Cymraeg newydd sydd wedi penderfynu ail afael yn yr iaith.
��ѿ��ý Radio Cymru
-
![]()
Fy Mag a Fi
Rhaglen sy'n clywed profiadau pobol o gael bag colostomi neu fag ileostomi.
��ѿ��ý Radio Cymru
-
![]()
-
![]()
Fy Nhad y Swltan
Hanes Keith Williams sy'n dod o hyd i'w rieni geni a chlywed bod ei dad yn Swltan ym Ma...
S4C
-
![]()
Fy Nhro Cyntaf
Sgyrsiau gonest gan griw ��ѿ��ý Sesh am brofiadau mawr bywyd. Y da, y drwg a'r doniol...
��ѿ��ý Radio Cymru
-
![]()
-
![]()
Fy Stori Fawr
Gall gohebu adael ei farc. Dyma leisiau newyddiadurol yn trafod eu stori fawr nhw.
��ѿ��ý Radio Cymru
-
![]()
-
![]()
Fyodor Dostoevsky - The Idiot
After years spent abroad, Prince Myshkin courageously returns to Russian society
��ѿ��ý Radio 4 Extra
-
![]()
Fyodor Dostoyevsky - The Double
Dostoyevsky's nightmare vision of a man whose life is usurped by his double.
��ѿ��ý Radio 4 Extra
-
![]()
إسرائيل تستهدف أهدافاً نووية و قادة عسكريين في إيران - Facebook
إسرائيل تستهدف أهدافاً نووية و قادة عسكريين في إيران
��ѿ��ý Live Streams